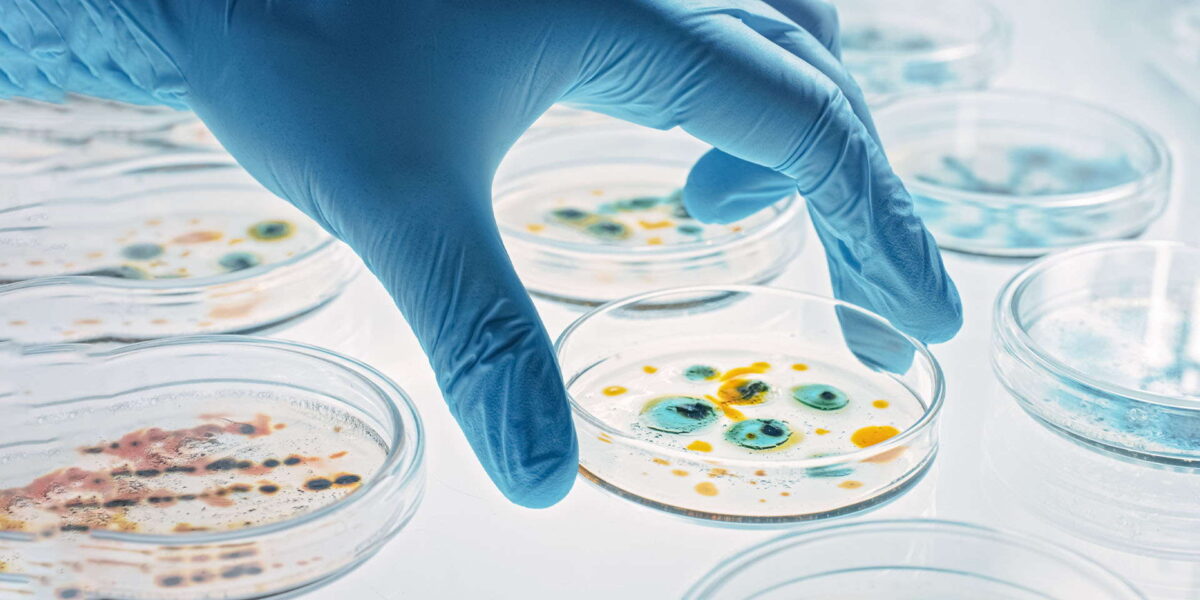

La radiología nos permite conocer el interior del cuerpo y crear una representación visual del funcionamiento de los órganos y tejidos revelando estructuras internas ocultas por la piel y huesos, ayudando a identificar de manera oportuna cualquier anormalidad en la anatomía y fisiología del cuerpo, resultando en un mejor diagnóstico y tratamiento para el paciente.
Los métodos y técnicas de obtención de imágenes utilizados en esta rama son conocidos por ser no invasivos, por ejemplo las radiografías crean imágenes que muestran tejidos, hueso y grasa mediante el uso de radiación de rayos X, los ultrasonidos muestran estructuras internas utilizando ondas ultrasónicas, mientras que con las resonancias magnéticas se obtienen imágenes gracias a poderosos imanes que interactúan con las moléculas de agua en los tejidos.
Los avances tecnológicos y computacionales de la actualidad han influido en el desarrollo y perfeccionamiento de los diversos métodos de obtención de imágenes, logrando mejores diagnósticos, tratamiento y prevención de las enfermedades.

- Radiología - Médicos Especialistas


- Radiología